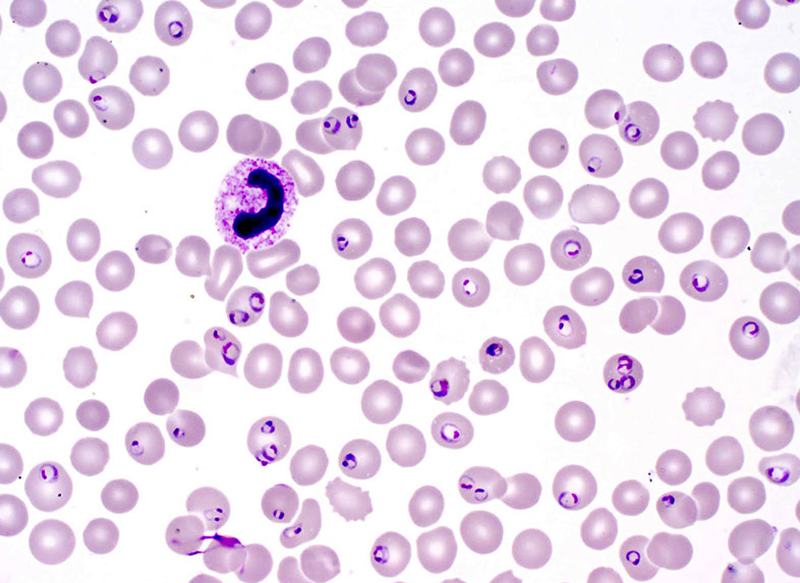
Trùng sốt rét có đặc điểm gì? 3 lưu ý phòng ngừa bệnh hiệu quả 1

Tốt nghiệp Khoa Dược trường Đại học Võ Trường Toản. Có nhiều năm kinh nghiệm trong ngành Dược. Hiện đang là giảng viên cho Dược sĩ tại Nhà thuốc Long Châu.
Trùng sốt rét có đặc điểm gì? 3 lưu ý phòng ngừa bệnh hiệu quả
21/06/2023
Mặc định
Lớn hơn
Sốt rét là bệnh truyền nhiễm do ký sinh trùng sốt rét Plasmodium gây ra, chủ yếu lây truyền qua trung gian là loài muỗi Anopheles. Vậy trùng sốt rét có đặc điểm gì? Bệnh có gây nguy hiểm không và có cách nào để phòng ngừa bệnh không?
Ký sinh trùng sốt rét từng là nỗi ám ảnh trước đây vì nhiều lần gây ra các trận đại dịch sốt rét. Có hơn 400.000 người chết do bệnh sốt rét trên thế giới hàng năm. Ngày nay chúng ta đã thành công ngăn chặn bệnh sốt rét nhưng chưa hoàn toàn loại trừ được bệnh. Hãy tham khảo bài viết sau để tìm hiểu trùng sốt rét có đặc điểm gì.
Trùng sốt rét có đặc điểm gì?
Trùng sốt rét có đặc điểm là có 5 chủng ký sinh và có 2 ký chủ gồm muỗi và cơ thể người
Trùng sốt rét có đặc điểm là có 5 chủng ký sinh và có 2 ký chủ gồm muỗi và cơ thể ngườiTrùng sốt rét có đặc điểm thế nào? Đây là loại ký sinh trùng thuộc chi Plasmodium, với 5 chủng ký sinh bao gồm:
- Plasmodium Falciparum: Đây là loại chủng ký sinh gây bệnh chủ yếu chokhoảng 70 - 80% số ca mắc sốt rét tại Việt Nam. Ký sinh trùng sốt rét này hầu như chỉ sinh sống tốt tại vùng khí hậu nóng ẩm.
- Plasmodium Vivax: Đây là ký sinh trùng ít phổ biến hơn, gây khoảng 20 - 30% số ca mắc, thường sinh trưởng nhiều tại những nơi có khí hậu lạnh.
- Plasmodium Malaria: Đậy là loại hiếm gặp ở Châu Á do đặc tính sinh trưởng kém ở môi trường nóng ẩm.
- Plasmodium Ovale: Loại ký sinh trùng này chưa được phát hiện tại Việt Nam.
- Plasmodium Knowlesi: Đây là một chủng ký sinh trùng sốt rét ở khỉ có khả năng gây bệnh cho người, là loài mới được phát hiện.
Việt Nam hiện có 3 chủng ký sinh trùng sốt rét phổ biến là P. falciparum, P.vivax và P.malariae. Cho đến nay, để chẩn đoán và phân biệt hình thể các loài ký sinh thuộc chi Plasmodium, người ta ứng dụng phương pháp phát hiện hình thể ký sinh trùng sốt rét bằng kỹ thuật lấy tiêu bản máu và nhuộm giemsa (Romanovski).
Muỗi cái Anopheles mang mầm bệnh hút máu và truyền các thoa trùng, cùng với chất kháng đông trong nước bọt vào ký chủ người. Như vậy, quá trình sinh sôi và gây bệnh của ký sinh trùng sốt rét chủ yếu liên quan đến 2 ký chủ:
- Trong cơ thể muỗi: Khi muỗi hút phải máu người nhiễm bệnh, sẽ nuôi dưỡng một lượng giao bào đực và cái, tạo ra số lượng lớn các thoa trùng, tập trung chủ yếu ở tuyến nước bọt của con muỗi.
- Trong cơ thể con người: Thoa trùng xâm nhập vào cơ thể người thông qua những vết đốt của muỗi. Sau khi lưu thông trong hệ thống tuần hoàn khoảng 2 - 3 ngày, chúng sẽ tập trung lại để phát triển số lượng tại gan.
Vòng đời của trùng sốt rét
Chu kỳ sống của ký sinh trùng sốt rét là giống nhau ở tất cả các loài Plasmodium.
Khi muỗi cái Anopheles hút phải máu có chứa bào tử từ một người bị sốt rét, quá trình truyền bệnh bắt đầu.
Sau khoảng 1 - 2 tuần, các giao tử bên trong muỗi bắt đầu sinh sản và tạo ra các thoa trùng.
Khi muỗi mang mầm bệnh cắn người khác, sẽ tiêm thoa trùng vào bên trong cơ thể, nhanh chóng đến gan và xâm nhập vào tế bào gan.
Các thoa trùng trưởng thành tại đây thành các thể phân liệt (schizonts).
Sau đó, các thể này bị vỡ ra và giải phóng các mảnh trùng (merozoites). Chu kỳ tiền hồng cầu là sự nhân lên của ký sinh trùng sốt rét trong gan.
Giai đoạn chu kỳ hồng cầu là các mảnh trùng di chuyển vào hồng cầu rồi bắt đầu quá trình nhân đôi vô tính. Trong đó, các mảnh trùng phát triển thành thể tư dưỡng rồi trưởng thành biến thành các thể phân liệt.
Các thể phân liệt này vỡ ra, từ đó giải phóng các thoa trùng. Chúng làm vỡ tế bào hồng cầu và giải phóng thoa trùng vào huyết tương sau từ 48 đến 72 giờ, gây ra các triệu chứng lâm sàng của bệnh sốt rét.
 Ký sinh trùng sốt rét gây ra triệu chứng lâm sàn là sốt rét
Ký sinh trùng sốt rét gây ra triệu chứng lâm sàn là sốt rétKhi vẫn còn trong giai đoạn hồng cầu, một số có thể biệt hóa thành thể hữu tính (các giao tử). Chu kỳ bào tử sinh xuất hiện khi muỗi đốt người, hút các giao tử đực và giao tử cái, bắt đầu quá trình sinh sản hữu tính.
Trong dạ dày của muỗi, hợp tử được tạo thành từ giao tử đực thâm nhập vào giao tử cái.
Các hợp tử biến đổi, dài ra, có khả năng di chuyển và phát triển thành trứng di động.
Trứng di chuyển chui qua mặt ngoài thành dạ dày của muỗi, phát triển thành thể trứng nang, vỡ ra, làm giải phóng các thoa trùng.
Các thoa trùng di chuyển đến tuyến nước bọt của muỗi và chờ để được truyền vào vật chủ mới và tiếp tục vòng đời của trùng sốt rét.
Thoa trùng của một số loài ký sinh trùng sốt rét như Plasmodium vivax và Plasmodium ovale tồn tại một giai đoạn bất hoạt gọi là thể ngủ (hypnozoites). Nếu không được điều trị, thể ngủ có thể cư trú ở gan trong nhiều tuần, thậm chí nhiều năm sau đó và sẽ gây tái phát triệu chứng bệnh sốt rét bằng cách xâm nhập vào dòng máu. Khi dùng các thuốc điều trị sốt rét để tiêu diệt ký sinh trùng trong máu, thể ngủ gần như không đáp ứng.
Nếu bệnh lây truyền qua truyền máu như sử dụng chung kim tiêm hoặc do nguyên nhân bẩm sinh, chu kỳ tiền hồng cầu trong vòng đời trùng sốt rét sẽ không xảy ra. Do đó, những cách thức lây truyền này không làm tái phát bệnh hay gây ra triệu chứng tiềm ẩn nào.
Khi các thoa trùng được giải phóng vào huyết tương trong giai đoạn hồng cầu, những triệu chứng lâm sàng của sốt rét sẽ xuất hiện. Nếu bệnh trầm trọng, sự tan máu có thể dẫn đến vàng da và thiếu máu, đây là gánh nặng cho lách để thực bào những hồng cầu nhiễm bệnh. Nếu nhiễm ký sinh trùng sốt rét Plasmodium falciparum hoặc nhiễm Plasmodium vivax mạn tính thì tình trạng thiếu máu thường nghiêm trọng hơn.
Giải pháp ngăn ngừa ký sinh trùng sốt rét
 Cách phòng bệnh sốt rét là loại bỏ nguồn tiếp xúc với muỗi
Cách phòng bệnh sốt rét là loại bỏ nguồn tiếp xúc với muỗiNgoài việc lưu ý ký sinh trùng có đặc điểm gì, mọi người nên quan tâm để cách phòng bệnh hơn chữa bệnh. Bệnh sốt rét là căn bệnh nguy hiểm nhưng lại chưa có vắc-xin đặc hiệu và thuốc điều trị. Vì vậy, cần chú trọng công tác phòng bệnh và chủ động thực hiện bằng những biện pháp như sau:
- Hạn chế nguy cơ tiếp xúc với muỗi: Tạo thói quen ngủ trong mùng, cả ban đêm lẫn ban ngày. Ngoài ra, bạn nên thoa kem hay xịt thuốc chống muỗi, sử dụng đèn bắt muỗi, đốt nhang đuổi muỗi...
- Vệ sinh nơi sinh sống sạch sẽ: Để hạn chế nơi cho muỗi cư ngụ và đẻ trứng. Bạn cần thường xuyên làm những công việc cụ thể là chặt bớt cỏ cây, bụi rậm, lấp ổ gà, ổ vịt, lật úp hoặc đậy nắp các vật dụng có chứa nước như thùng, lu, gáo, lốp xe...
- Phun hóa chất diệt muỗi tại khu vực: Khi bệnh sốt rét vào lúc cao điểm, đặc biệt là vào mùa mưa, người dân nên báo cho cơ quan chức năng để phun hóa chất diệt muỗi tại các ổ chứa muỗi nhằm ngăn ngừa sự lây lan ký sinh trùng sốt rét.
- Khai báo y tế: Người được lấy máu cần khai báo y tế chi tiết, rõ ràng, đặc biệt khi sống trong vùng sốt rét hoặc từng có tiền sử mắc bệnh truyền nhiễm để đảm bảo an toàn khi truyền máu cho bệnh nhân.
Khi người bệnh xuất hiện các triệu chứng nghi ngờ do ký sinh trùng sốt rét gây ra, bệnh nhân cần đến bệnh viện ngay để được chẩn đoán chính xác và chữa trị sớm nhất có thể nhằm phòng ngừa các biến chứng của bệnh và giảm nguy cơ tử vong do sốt rét.
Quỳnh Trang
Nguồn tham khảo: Tổng hợp
Có thể bạn quan tâm
Các bài viết liên quan
Sốt 39 độ uống thuốc không hạ nên xử lý như thế nào?
Bị sốt nên uống gì? Những thức uống giúp hồi phục sức khỏe
Trẻ đang uống kháng sinh mà vẫn sốt: Nguyên nhân và cách xử trí an toàn
Có thai tuần đầu có bị sốt không? Những điều bạn cần biết
Bị sốt đau họng nhức mỏi toàn thân là do đâu? Cách phòng ngừa?
Trẻ sơ sinh bao nhiêu độ là sốt? Cách hạ sốt hiệu quả
Cách chăm sóc người bị sốt hiệu quả, an toàn và những lưu ý cần biết
Sốt phát ban có được ra gió không?
[Infographic] Hệ miễn dịch sẽ làm gì khi bạn bị sốt?
Tìm hiểu mối liên hệ khi bị sốt có làm tăng huyết áp hay không?
:format(webp)/Option_1_2_2d9677e5fd.png)
:format(webp)/Option_1_1_2a84e0cd00.png)
:format(webp)/ds_khanh_tuong_1_592bf2eb07.png)